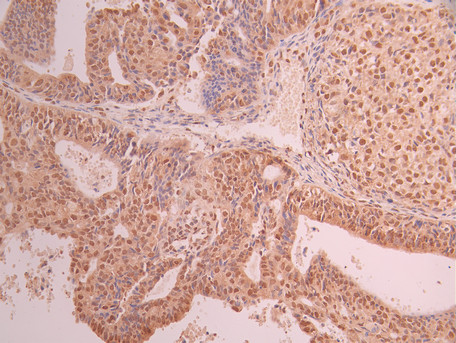

-
中文名稱:NOX4 Recombinant Monoclonal Antibody
-
貨號:CSB-RA948463A0HU
-
規格:¥1320
-
圖片:
-
Western Blot
Positive WB detected in: SH-SY5Y whole cell lysate(30μg), MCF-7 whole cell lysate(30μg)
All lanes: NOX4 antibody at 1:1000
Secondary
Goat polyclonal to rabbit IgG at 1/40000 dilution
Predicted band size: 67 kDa
Observed band size: 67 kDa
Exposure time:2min40s -
IHC image of CSB-RA948463A0HU diluted at 1:100 and staining in paraffin-embedded human ovarian cancer performed on a Leica BondTM system. After dewaxing and hydration, antigen retrieval was mediated by high pressure in a citrate buffer (pH 6.0). Section was blocked with 10% normal goat serum 30min at RT. Then primary antibody (1% BSA) was incubated at 4°C overnight. The primary is detected by a Goat anti-rabbit polymer IgG labeled by HRP and visualized using 0.05% DAB.
-
IHC image of CSB-RA948463A0HU diluted at 1:100 and staining in paraffin-embedded human kidney tissue performed on a Leica BondTM system. After dewaxing and hydration, antigen retrieval was mediated by high pressure in a citrate buffer (pH 6.0). Section was blocked with 10% normal goat serum 30min at RT. Then primary antibody (1% BSA) was incubated at 4°C overnight. The primary is detected by a Goat anti-rabbit polymer IgG labeled by HRP and visualized using 0.05% DAB.
-
Overlay Peak curve showing Hela cells stained with CSB-RA948463A0HU (red line) at 1:100. The cells were fixed in 4% formaldehyde and permeated by 0.2% TritonX-100 for 10min. Then 10% normal goat serum to block non-specific protein-protein interactions followed by the antibody (1ug/1*106cells) for 45min at 4℃. The secondary antibody used was FITC-conjugated goat anti-rabbit IgG (H+L) at 1/200 dilution for 35min at 4℃.Control antibody (green line) was Rabbit IgG (1ug/1*106cells) used under the same conditions. Acquisition of >10,000 events was performed.
-
-
其他:
產品詳情
-
Uniprot No.:
-
基因名:
-
別名:NADPH oxidase 4 (EC 1.6.3.-) (Kidney oxidase-1) (KOX-1) (Kidney superoxide-producing NADPH oxidase) (Renal NAD(P)H-oxidase), NOX4, RENOX
-
反應種屬:Human
-
免疫原:A synthesized peptide from human NOX4 protein
-
免疫原種屬:Homo sapiens (Human)
-
標記方式:Non-conjugated
-
克隆類型:Monoclonal
-
抗體亞型:Rabbit IgG
-
純化方式:Affinity-chromatography
-
克隆號:7F3
-
濃度:It differs from different batches. Please contact us to confirm it.
-
保存緩沖液:Preservative: 0.03% Proclin 300
Constituents: 50% Glycerol, 0.01M PBS, PH 7.4 -
產品提供形式:Liquid
-
應用范圍:ELISA, WB, IHC, FC
-
推薦稀釋比:
Application Recommended Dilution WB 1:500-1:2000 IHC 1:50-1:200 FC 1:50-1:200 -
Protocols:
-
儲存條件:Upon receipt, store at -20°C or -80°C. Avoid repeated freeze.
-
貨期:Basically, we can dispatch the products out in 1-3 working days after receiving your orders. Delivery time maybe differs from different purchasing way or location, please kindly consult your local distributors for specific delivery time.
-
用途:For Research Use Only. Not for use in diagnostic or therapeutic procedures.
相關產品
靶點詳情
-
功能:Constitutive NADPH oxidase which generates superoxide intracellularly upon formation of a complex with CYBA/p22phox. Regulates signaling cascades probably through phosphatases inhibition. May function as an oxygen sensor regulating the KCNK3/TASK-1 potassium channel and HIF1A activity. May regulate insulin signaling cascade. May play a role in apoptosis, bone resorption and lipolysaccharide-mediated activation of NFKB. May produce superoxide in the nucleus and play a role in regulating gene expression upon cell stimulation. Isoform 3 is not functional. Isoform 5 and isoform 6 display reduced activity.; Involved in redox signaling in vascular cells. Constitutively and NADPH-dependently generates reactive oxygen species (ROS). Modulates the nuclear activation of ERK1/2 and the ELK1 transcription factor, and is capable of inducing nuclear DNA damage. Displays an increased activity relative to isoform 1.
-
基因功能參考文獻:
- Metabolic syndrome in Brazilian NAFLD patients most likely results from common allelic variants in a large number of genes, including CYBA and NOX4, that interact with each other, each of which alone determines a modest risk. PMID: 30087027
- This genome-wide association study of severe diabetic retinopathy suggests new evidence for the involvement of the NOX4 gene. PMID: 30178632
- These results suggest the specific involvement of Nox4 and Nox2 subunits as physiologically relevant endothelial sources of H2O2 generation that contribute to the endothelium-dependent vasodilatation of renal arteries and therefore have a protective role in kidney vasculature. PMID: 30125808
- NOX4 is induced in early alcoholic liver injury and regulates CCR2/CCL2 mRNA stability thereby promoting recruitment of inflammatory cells and production of proinflammatory cytokines. PMID: 28383062
- Study reveals the novel function of NOX4 in reprogramming aerobic glycolysis initiated by activated Kras and inactivated p16 in pancreatic ductal adenocarcinoma (PDAC), indicating its potential as a therapeutic target for PDAC and other cancers. PMID: 28232723
- Human post-mortem and animal studies have identified elevated NOX2 and NOX4 levels in the injured brain, suggesting that these two NOXs are involved in the pathogenesis of Traumatic brain injury (TBI) PMID: 29571125
- our data demonstrate that hypoxia strongly potentiates the peroxide-mediated induction of hepcidin via STAT3 signaling pathway. Moreover, oxidases such as NOX4 or artificially overexpressed urate oxidase (UOX) can induce hepcidin PMID: 29459227
- Nox4 and its linked ER stress were shown to mainly contribute to eNOS uncoupling and its associated signaling in endothelial cells PMID: 28916474
- Our data suggest that TGF-beta1-induced chemokinesis in PDAC cells is mediated through a RAC1/NOX4/ROS/p38 MAPK cascade. PMID: 29039574
- GATA4 may inhibit diabetesinduced endothelial dysfunction by acting as a transcription factor for NOX4 expression. PMID: 29138836
- The results demonstrate that the heightened sensitivity of the brain to ischemic damage is due to an organ-specific role of NOX4 in blood-brain barrier endothelial cells and neurons. PMID: 29087944
- PTEN inhibits replicative senescence-induced MMP-1 expression by regulating NOX4-mediated reactive oxygen species in human dermal fibroblasts. PMID: 28557373
- The NADPH-dependent reduction of cytochrome c or cytochrome b5 by purified Nox4 DH domain was found regulated by the H2O2 concentration, and C546L and C547L mutants showed lower rates of the hemeprotein reduction. PMID: 29365138
- We demonstrated that small interfering RNA (siRNA)-mediated knockdown of PRR, Nox2 and Nox4 significantly reduced the HG-induced stimulation of VEGF. On the other hand, Nox4 overexpression significantly potentiated PRR-induced stimulation of VEGF under hyperglycemia in ARPE-19 cells. PMID: 28840773
- Studies indicate that NADPH oxidase 4 (Nox4) is present in fibroblasts, a primary cell of the adventitia, and matches the adventitial location of ROS production in pulmonary arterial hypertension [Review]. PMID: 29047077
- Serum Gal-3 and Nox4 levels were significantly elevated and correlated in 26 human pulmonary arterial hypertension patients when compared with 14 age- and sex-matched healthy controls. PMID: 28431936
- we demonstrated that when NOX4 expression was knocked down by siRNAs, cell proliferation, cell-cycle and apoptosis, migration and invasion were significantly altered in CRC cell lines HCT116 and LOVO. Meanwhile, NOX4 promoted cancer cell proliferation and apoptosis, migration and invasion by regulating the expression of relevant genes. PMID: 28422720
- Nox4 not only mediated TGF-beta1- induced collagen type I synthesis but also the expression of the myofibroblast markers alpha-SMA and fibronectin 1. PMID: 27576129
- High NOX4 expression is associated with drug resistance in renal cell carcinoma. PMID: 29051480
- Nox4 potentially mediates HGinduced HKC cell apoptosis. PMID: 28487945
- Our results showed that lowering NOX4 oxidase below physiological level leads to cellular senescence of vascular smooth muscle cells PMID: 27655718
- Extracellular advanced oxidative protein products accumulation triggered NOX4-dependent reactive oxygen species production, which activated ERK1/2 and p38 MAPK, and induced HaCaT cell apoptosis by activating caspase 3 and PARP-1. PMID: 27155970
- The results establish a link between BRAF(V600E) and NOX4, which is confirmed by a comparative analysis of NOX4 expression in human (TCGA) and mouse thyroid cancers. PMID: 27401113
- This study also showed that UCH-L1 promotes angiogenesis of HUVECs, as well as invasion in cancer cells, by up-regulating ROS by deubiquitination of NOX4, suggesting that UCH-L1 plays a key role in angiogenesis of HUVECS by regulating ROS levels by deubiquitination of NOX4. PMID: 29128359
- The results reveal that NOX4 promotes glycolysis, contributing to non-small cell lung cancer cells growth, and supports glutaminolysis for oxidative resistance. PMID: 27989748
- Metformin attenuates idiopathic lung fibrosis development via suppression of myofibroblast NOX4 expression. PMID: 27576730
- Letter: airway smooth muscle cell NOX4 expression is increased in vivo and in vitro in COPD. PMID: 27435477
- These data suggested that t-BHP induced both apoptosis and necroptosis in endothelial cells which was mediated by ROS and p38MAPK. ROS derived from NADPH oxidase and mitochondria contributed to t-BHPL and t-BHPH-induced apoptosis and necroptosis, respectively PMID: 28088644
- These processes are mediated upstream by the reactive oxygen species (ROS)-producing enzyme Nox4. PMID: 28182006
- data suggest that monocytic Nox4 is a central regulator of actin dynamics, and induction of Nox4 is the rate-limiting step in metabolic stress-induced monocyte priming and dysfunction associated with accelerated atherosclerosis and the progression of atherosclerotic plaques PMID: 23825596
- findings demonstrate that manipulation of the host PI3K/Akt signaling pathway and Nox4 gene expression is a novel mechanism involved in T. gondii survival and proliferation PMID: 23824914
- Loss of NOX4 increases actomyosin levels and favours an epithelial to amoeboid transition contributing to tumour aggressiveness. PMID: 27941881
- NOX2, NOX4, and mitochondrial-derived reactive oxygen species contribute to angiopoietin-1 signaling and angiogenic responses in endothelial cells. PMID: 28351775
- Mechanistically, HO-1 induction by all CRLPs requires NADPH oxidase 4, with PUFA-containing particles additionally dependent upon mitochondrial reactive oxygen species.These studies define new molecular pathways coupling endothelial cell activation by model CMRs with adaptive regulation of Nrf2-dependent HO-1 expression PMID: 27185859
- NOX4 knockout cell lines showed reduced cell proliferation with an increase of sub-G1 cell population and the decrease of S/G2/M population, and resulted in a dramatic decrease in invadopodium formation and the invasive activity. NOX4 deficiency caused a decrease in focal adhesions and cell migration in HeLa cells. The results suggest that NOX4 is required for both efficient proliferation and invasion of HeLa cells. PMID: 28099519
- Thioredoxin attenuates oxidized low-density lipoprotein induced oxidative stress in human umbilical vein endothelial cells by reducing NOX2-NOX4 activity. PMID: 28688762
- Nox4-derived H2O2 in part activates Nox2 to increase mitochondrial ROS via pSer36-p66Shc, thereby enhancing VEGFR2 signaling and angiogenesis in endothelial cells. PMID: 28424170
- TGF-beta1 increases NADPH oxidase 4 (NOX4) mRNA and protein expression in normal human lung fibroblasts (NHLFs) and causes nuclear export of HDAC4. PMID: 28336812
- Nox4 should contribute to the pathological processes insubarachnoid hemorrhage(SAH)-induced early brain injury (EBI), and there was not an overlay effect of Nox2 inhibition and Nox4 inhibition on preventing SAH-induced EBI. PMID: 28330417
- TGFbeta1 was found to induce Nox4 mRNA expression and total collagen release by these cells (P < 0.05; n = 4), and both responses are blocked by Smad3 inhibitor SIS3. Suppressing Nox4 gene transcription with Adv-Nox4i completely attenuated TGFbeta1-stimulated H2O2 release and collagen production by conjunctival fibroblasts PMID: 28605812
- CD44V6 is part of a positive-feedback loop with TGFbeta1/TGFbetaRI signaling that acts to increase NOX4/ROS production, which is required for myofibroblast differentiation, myofibroblast differentiation, myofibroblast extracellular matrix production, myofibroblast invasion, and myofibroblast contractility. PMID: 28389561
- Endoplasmic reticulum stress triggers a localized signaling module on the ER surface involving Nox4-dependent calcium mobilization, which directs local Ras activation through ER-associated, calcium-responsive RasGRF. PMID: 27856453
- PI3K/AKT signaling only occurs when FLT3-ITD is expressed at the plasma membrane and is required for the production of NOX-generated ROS. ER retention of FLT3-ITD resulted in NOX4 deglycosylation and p22(phox) protein degradation. PMID: 27870947
- NOX4 upregulation confers anoikis resistance. PMID: 28081539
- these data demonstrate that increased expression and activation of NOX4, which might result from increased TGFbeta1 levels seen during aging, induces a proinflammatory phenotype in VSMCs, enhancing atherosclerosis. PMID: 27986445
- The ROS levels of the study group decreased obviously before irradiation (P<0.01), however, the radiation-induced ROS of the study group was at a high level even when irradiation had been terminated for 2 h (P<0.01). Moreover, NOX2 and NOX4 levels and total SOD activity decreased (P<0.01), while the levels of SOD1 were stably maintained (P>0.05). PMID: 28260074
- alkali burns markedly upregulated the transcription and expression of Nox2 and Nox4 in human or mouse corneas. PMID: 27221536
- The NOX4 and TLR2 pathways played important roles in the biological effects mediated by Bletilla striata polysaccharide b. PMID: 27151672
- it was demonstrated that elevated uric acid promoted ROSinduced tubular cell apoptosis by upregulating Nox4 expression. PMID: 27052425
- expression of MATER and NOX4 proteins are closely related to the follicular development and ovulation with particular regard for ovarian aging PMID: 27515505
顯示更多
收起更多
-
亞細胞定位:Endoplasmic reticulum membrane; Multi-pass membrane protein. Cell membrane; Multi-pass membrane protein. Cell junction, focal adhesion. Note=May localize to plasma membrane and focal adhesions. According to PubMed:15927447, may also localize to the nucleus.; [Isoform 4]: Nucleus. Nucleus, nucleolus.
-
組織特異性:Expressed by distal tubular cells in kidney cortex and in endothelial cells (at protein level). Widely expressed. Strongly expressed in kidney and to a lower extent in heart, adipocytes, hepatoma, endothelial cells, skeletal muscle, brain, several brain t
-
數據庫鏈接:
Most popular with customers
-
-
YWHAB Recombinant Monoclonal Antibody
Applications: ELISA, WB, IHC, IF, FC
Species Reactivity: Human, Mouse, Rat
-
Phospho-YAP1 (S127) Recombinant Monoclonal Antibody
Applications: ELISA, WB, IHC
Species Reactivity: Human
-
-
-
-
-